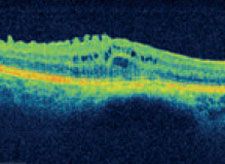
Aufnahme - Epiretinale Membran
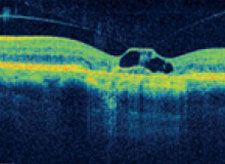
Abbildung - Vitreomamakuläre Traktion mit geografischer Atrophie

Makulavorsorge in der Augenarztpraxis Dr. Martin Liegl
Plötzliche oder schleichende Sehverschlechterungen können oftmals nicht durch alleinige Refraktionskorrektur, beispielsweise durch Brillen oder Kontaktlinsen, korrigiert werden. Gerade im höheren Lebensalter spielen Erkrankungen der Makula, der Region des schärfsten Sehens, eine zunehmend substantiellere Rolle in der Ursache der Sehminderung.
Zu diesen Erkrankungsformen zählt unter anderem die Altersassoziierte Makuladegeneration, die in einer sogenannten trockenen Form ohne Gefäßneubildung und einer „feuchten“ Form mit Bildung neuer Gefäße auftreten kann. Eine Differenzierung mit rein klinischen Untersuchungstechniken ist nicht selten schwierig, oftmals ist zur Sicherstellung des Befundes und damit zur Einleitung der richtigen Therapie eine aufwendige technische Untersuchung nötig. Wir können Ihnen alle Untersuchungen, wie beispielsweise eine Farbstoffuntersuchung (Fluoreszenzangiographie, FLA) oder aber eine hochauflösende Schnittbilduntersuchung mittels der optischen Köherenztomographie (3D-OCT) mit einem Gerät der neuesten Generation in unserer Praxis, ohne Sie in ein entfernt liegendes Diagnostikzentrum schicken zu müssen, bieten.
Optische Kohärenztomographie (OCT)
Mit der Entwicklung neuer Medikamente, die in das Auge injiziert werden um so beispielsweise ein Makulaödem (eine Flüssigkeitsansammlung im Zentrum des schärfsten Sehens) bei verschiedenen Grunderkrankungen zu therapieren, sind diffizile Untersuchungstechniken nötig, die oftmals nur in großen Zentren zu finden sind.
Erkrankungen wie die diabetische Retinopathie, die feuchte Makuladegeneration (AMD) oder aber auch venöse Verschlüße am Auge (ZVT), um nur einige zu nennen, können seit kurzem mittels intravitreal verabreichter Medikamente (IVOM) suffizient behandelt werden. Um eine zügige Bearbeitung durch Ihre Krankenkasse zu gewährleisten sind Nachweise zur Indikationsstellung notwendig.
Die optische Koherenztomographie in spectral Technik (auch bekannt als „Spectralis“, Fourier Domain OCT oder 3D – OCT) ist die modernste und genauste Methode zur Darstellung von Netzhautveränderungen.
In unserer Praxis halten wir eines der modernsten Geräte der renommierten deutschen Firma Carl Zeiss Meditec bereit, das Cirrus HD-OCT. So können ohne zeitliche Verzögerung, nach eingehender klinischer Untersuchung und Indikationsstellung, noch vor Ort alle Möglichkeiten zur Diagnose, Medikamentenbeantragung und Therapie eingeleitet werden. Ein Vorteil für Sie, da keine weiteren Termine und Überweisungen für Untersuchungen, keine langen Wartezeiten in anderen Zentren/Kliniken etc. von Nöten sind.
EINZIGARTIGE BILDER IN HIGH-DEFINITION
Mithilfe modernster Algorithmen und Analyseverfahren kann das Cirrus HD-OCT einzigartig detaillierte HD-Darstellungen erzeugen.
Altersbedingte Makuladegeneration
Chorioretinitis centralis serosa
Epiretinale Membran
Vitreomamakuläre Traktion mit geografischer Atrophie
DETAILDARSTELLUNGEN IN HIGH-DEFINITION
Schichtdarstellung und Abweichungsdarstellung
- HD-OCT-Bilder sind hochauflösende Querschnitte, welche die Pathologie bis ins kleinste Detail darstellen.
- HD-RPE-Schichtdarstellung zeigt das Ausmaß subfovealer Läsion sowie die Lage von Drusen an.
- HD-ILM-Schichtdarstellung zeigt, dass die Netzhautgrube noch vorhanden ist.
- RPE-Abweichungsdarstellung richtet die RPE-Struktur mit dem Fundus aus. Hierzu wird die tatsächliche RPE-Kontur von einer regelmäßigen RPE-Kontur abgezogen.
Netzhautschichten bis ins kleinste Detail
- Das HD-OCT-Bild zeigt die Netzhautschichten bis ins kleinste Detail. Die genaue Position dieses Bildes ist auf dem LSO-Fundusbild angegeben.
- Das LSO Fundusbild zeigt eine Flüssigkeitsansammlung sowie die Besonderheiten der Netzhautgefäße.
- Eine HD-Dickedarstellung zeigt eine unregelmäßige Netzhautdicke.
- Die Überlagerung der Dickedarstellung zeigt auf, in welchem Zusammenhang die Verdickung zum Fundus steht.
Deformation der Netzhautkontur
- Das HD-OCT-Bild zeigt eine Deformation der normalen Netzhautkontur.
- Eine hochaufl ösende ILM-Schichtdarstellung zeigt ILMFalten infolge von Traktion der epiretinalen Membran.
- HD-Dickendarstellung zeigt eine Verdickung des Netzhautgewebes.
- Eine Überlagerung der Gewebeschichten stellt das Ausmaß der mit dem Fundus ausgerichteten epiretinalen Membran dar.
Verzerrung des Netzhautgewebes
- Das HD-OCT-Bild stellt die Verbindung zwischen Glaskörper und Fovea sowie die Verzerrung des Netzhautgewebes dar.
- Das Fundusbild mit einer Überlagerung der Dickedarstellung zeigt, wie sich die zugrundeliegende Erkrankung im Fundusbild auswirkt.
- Eine hochauflösende ILM-Schichtdarstellung zeigt die zylindrische Verzerrung der Traktion auf der inneren Grenzmembran.
- Eine Überlagerung mit dem Fundusbild zeigt, wo sich die Reflexionseigenschaften der Gewebeschichten infolge
der Störung der Fotorezeptoren geändert haben.
Fluoreszenzangiographie (FLA)
Die proliferative diabetische Retinopathie (PDR), die neovaskuläre („feuchte“) Form der altersassoziierten Makuladegeneration (wet AMD) sowie der Zentralvenenverschluss (ZVT) sind nur einige Beispiele in denen es zu einer Neovaskularisation, dass heisst einer Neubildung von krankhaften Gefäßen kommt, die spezieller Diagnostik und in Folge auch adäquater Therapie bedarf.
Die Fluoreszenzangiographie ist noch heute der Goldstandard im Nachweis dieser neovaskulären Veränderungen. Wir können diese Untersuchung mittels eines hochmodernen digitalen Fluorszenzangiographie Systems direkt vor Ort in unserer Praxis durchführen. So können behandlungsbedürfte Veränderungen frühzeitig erkannt und behandelt werden.